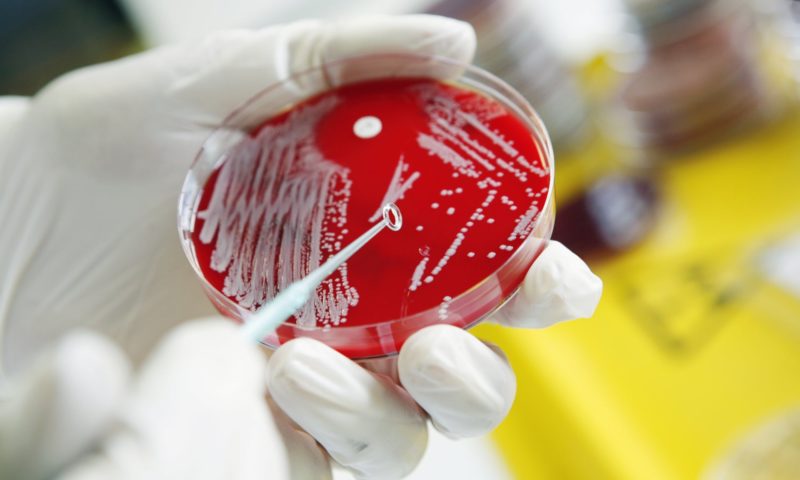
Utilizarea Insectelor ca Armă Biologică

Incorect Politic
August 23, 2019

Via Justițiarul:
Congresul Statelor Unite a votat pentru ca Pentagonul să fie investigat pentru utilizarea insectelor ca armă biologică
Într-un episod din viața reală a X-Files (Dosarele X), membrilor Congresului Statelor Unite li s-a raportat că Pentagonul ar putea avea arme biologice pentru un război entomologic sub formă de căpușe sau alte insecte, care au provocat răspândirea bolii Lyme. „Roll Call”, un ziar centrat pe Congres relatează că, în 11 iulie, acesta a decis în secret, prin vot, să sprijine adăugarea unui amendament la proiectul de lege pentru autorizația de apărare din 2020, care ar trebui să solicite Ministerului Justiției să examineze dacă sunt acoperite de Pentagon / CIA / DoD întrebuințarea ca arme bilogice a căpușelor sau altor insecte.
Potrivit „Roll Call”, deputatul republican din New Jersey, Christopher Smith, a scris amendamentul solicitând inspectorului general „să efectueze o examinare a faptului că Departamentul Apărării (DoD) a experimentat pe căpușe și alte insecte utilizarea lor ca armă biologică între anii 1950 și 1975.” Smith, de asemenea, în mod ironic, co-președinte al Congresului privind Boala Lyme, a mai spus pentru „Roll Call”: „Avem nevoie de răspunsuri și avem nevoie de ele acum.”
În primul rând, să definim războiul biologic pe baza Convenției Privind Armele Biologice din anul 1972. Definiția unui agent BW (bioarmă) este destul de clară : „Agenți microbieni sau alți agenți biologici, sau toxine, indiferent de originea sau metoda lor de producție, de tipuri și în ce cantități care nu au nicio justificare pentru scopuri profilactice, de protecție sau în alte scopuri pașnice.”
Este un fapt incontestabil faptul că SUA a avut o politică de lungă durată pentru experimentarea umană a acestor arme, experimentând asupra populației sale civile decenii, începând cu anii 1950 (Războiul Rece), făcând un total de 239 de teste „război cu germeni” pe zone populate, potrivit „The Washington Post”.
Chiar înainte de Războiul Rece și cel de-al doilea război mondial, SUA a fost implicată în experimente eugenice precum sterilizarea forțată pentru persoane indezirabile în cel puțin 24 de state – înainte ca chiar naziștii să fie implicați în aceeași practică ani mai târziu. De fapt, în Statele Unite au existat un număr de 64.000 de cazuri de sterilizare forțată, dar acest număr nu ține cont de sterilizările care au avut loc după 1963. În acea perioadă, femei din diferite grupuri minoritare au fost selectate pentru sterilizare în diferite experimente diferite. Numărul crește și mai mult dacă se iau în considerare sterilizările după 1963, crescând numărul de sterilizări în Statele Unite la 80.000. Mișcarea eugenică americană a primit finanțări extinse de la diverse fundații corporative, inclusiv Instituția Carnegie, Fundația Rockefeller și căile ferate Harriman. În 1972, mărturii ale Comisiei Senatului Statelor Unite a scos la lumină că au fost efectuate cel puțin 2.000 de sterilizări involuntare la femei negre sărace, fără consimțământul sau cunoștința lor, potrivit unui articol aprofundat despre eugenia din SUA, intitulat „6.6: Eugenics în Statele Unite.”
Acest autor a scris anterior despre un proiect de război biologic utilizat în timpul Războiului Rece,Operațiunea LAC sau (Operațiune de Acoperire pe Suprafață Mare). Da, acesta este istoricul secret de experimente anterioară. Armata Statelor Unite, în interiorul SUA continentale, a experimentat pulverizând particule de sulfură de cadmiu-zinc pe o mare parte din SUA în mai multe orașe, incluzând St.Louis și Texas; acel proiect a fost cunoscut sub numele de Operation LAC (Large Area Coverage). Aceasta a fost dezvăluită de o profesoară de sociologie de la Colegiul Comunitar St Louis, Lisa Martino-Taylor. Pentru recapitulare, armata americană a testat în secret și substanțe chimice cancerigene pe rezidenții necunoscători ai Canadei din Winnipeg și Alberta, în timpul Războiului Rece, în teste legate de armamentul care implică ingrediente radioactive menite să atace Uniunea Sovietică, a relatat Activist Post.
Incidentele s-au produs între 9 iulie 1953 și 1 august 1953, când au pulverizat șase kilograme de sulfură de cadmiu-zinc pe cetățenii din Winnipeg din avioanele armatei americane. Armata a revenit apoi 11 ani mai târziu în 1964 și a repetat experimentele în alte părți din Canada, inclusiv Suffield, Alberta, potrivit profesoarei de sociologie Lisa Martino-Taylor, aspect relatat de „National Post” https://nationalpost.com/news/canada/u-s-secretly-tested-carcinogen-in-western-canada-during-the-cold-war-researcher-discovers .
Și mai departe, Statele Unite au susținut teste cu arme biologice și chimice în aer liber în cel puțin patru state – Alaska, Hawaii, Maryland și Florida – în anii ’60, în efortul de a dezvolta apărarea împotriva unor astfel de arme, potrivit documentelor Pentagonului. Conform documentelor, cochilii și bombele de artilerie au fost umplute cu agenți patogeni precum sarinul și gazele VX. Aceste teste au făcut parte din Proiectul 112, un program militar din anii ’60 -’70 pentru testarea armelor chimice și biologice și a apărărilor împotriva lor. Părțile din programul de testare efectuat pe navele marine s-au numit Project SHAD sau Shipboard Hazard and Defense, a informat Miami Herald.
De asemenea, CIA a făcut mai multe experimente umane neetice în Statele Unite. Într-un caz, au injectat material radioactiv pacienților din spital, fără consimțământul lor. Alte experimente au fost efectuate asupra femeilor însărcinate din Nashville, cărora li s-a administrat un cocktail radioactiv din fier prin ingerare, astfel încât cercetătorii să poată determina dacă cancerul ar putea fi transmis descendenților lor. Chiar și copiii au fost hrăniți cu ovăz radioactiv ca parte a unui „club de științe”, a spus sociologul Martino-Taylor.
Raportul anterior nu observa dacă experimentele din Canada au fost conectate la Operațiunea LAC, deși are mai multe asemănări cu proiectul sau dacă acesta a fost o parte mai mare a Proiectului 112https://en.wikipedia.org/wiki/Project_112 .
Cu toate acestea, de ani buni, guvernul canadian a negat faptul că a testat orice bioarme în Alaska și Alberta, precum și pulverizarea „armelor biologice simulate în orașele din America de Nord, inclusiv Winnipeg”. ,,Agenți Patogeni pentru Război” al istoricului Universității din Vestul Ontario, Donald Avery, remarcă faptul că oamenii de știință canadieni au fost intim implicați în cercetarea bioarmelor din SUA până în 1969, atunci când președintele Richard Nixon a încheiat unilateral programul. Cantități semnificative de toxine, inclusiv sarin și agentul neuroparalizant VX, au fost stocate în Canada, Suffield până cel puțin în 1989, a relatat „The Star” https://www.thestar.com/news/canada/2013/06/26/canada_played_key_role_in_us_uk_biological_weapons_programs_walkom.html.
Statele Unite ale Americii s-ar fi desprins de programul de arme biologice la sfârșitul anilor 1960 și au convenit într-un tratat din 1997, „Convenția privind interzicerea dezvoltării, producției, stocării și utilizării armelor chimice” pentru a distruge toate armele sale chimice. Scopul „a fost să descurajăm utilizarea armelor biologice împotriva Statelor Unite și aliaților săi și să ripostăm în cazul în care descurajarea nu reușea”, a explicat guvernul. „Fundamental pentru dezvoltarea unei strategii de descurajare a fost necesitatea unui studiu și o analiză amănunțită a vulnerabilității noastre la atacul pe ascuns sau direct.”
Timp de ani, multe zvonuri au înconjurat Insula Plum din New York și Fort Detrick din Maryland (aceeași bază din care a provenit antraxul ce a fost folosit în atacuri asupra mass-media și politicienilor după 11 septembrie) ar putea să fi infectat insecte pentru teste cu arme biologice și apoi eliberate în afara laboratorului, într-un experiment pe viu, care ducea la răspândirea virusurilor / bolilor. Fort Detrick găzduiește Bio-Laboratorul Top Secret, Battelle (Centrul Național de Analiză și Control-Măsuri Biodefensive – NBACC), în cadrul unui contract al Departamentului de Securitate Internă (DHS) al SUA pentru ultimul deceniu. Battelle a primit un contract federal de 344,4 milioane USD (2006 – 2016) și un alt contract de 17,3 milioane USD (2015-2026) de către DHS.
R.K.D. Peterson, în 1990, la Universitatea din Nebraska, a detaliat istoria insectelor care se presupune că sunt folosite ca arme biologice, cunoscut și sub numele de război entomologic (EW) de-a lungul istoriei (http://archive.is/Edf0O).
Există trei forme principale de război entomologic – insectele folosite direct ca arme, insectele folosite pentru distrugerea culturilor și insectele folosite ca vectori pentru a provoca boala, potrivit lui Ryan C. Gott, Ph.D. Potrivit lui Peterson, războiul civil american din 1861-1865, a marcat primul conflict cu presupusă utilizare a unei insecte ca armă de război. Confederația a acuzat Uniunea că a introdus în mod deliberat ploșnița arlechin (Murgantia histrionica) în Sud.
Ploșnița arlechin (Murgantia histrionica).
Din cauza acestui dăunător, au rezultat daune cutanate groaznice. Această afirmație nu a fost niciodată dovedită, iar acum se pare că ploșnița arlequin s-a mutat de una singură în Sud din Mexic. Cu toate acestea, este posibil ca oamenii să fi ajutat la mișcarea acestui dăunător. Relațiile de boală (microbiene și insecte vector) au fost elucidate la începutul secolului XX. Imediat ce mecanismele au fost cunoscute, planificatorii militari au început să le aplice ca posibili agenți de război.
Următoarea presupusă utilizare a insectelor ca armă biologică a fost în 1943, când Hitler a acceptat să înființeze la Posen o stație de cercetare a armelor biologice SS. Pe măsură ce rușii s-au apropiat mai mult de stația de cercetare, lucrările s-au accelerat apoi la stație, dar nu s-au făcut progrese reale înainte ca rușii să ocupe stația în martie 1945. La stația de cercetare a bioarmelor Posen, germanii au lucrat la boli precum ciuma, holera, tifosul și febra galbenă.
De asemenea, au efectuat experimente cu privire la fezabilitatea folosirii insectelor, cum ar fi gândacul de cartofi de Colorado, pentru a ataca culturile de cartofi ale aliaților. Germanii au fost acuzați că aruncau cutii de carton umplute cu gândaci de cartofi Colorado peste Anglia din 1941-1943, potrivit cercetărilor lui Peterson. Cu toate acestea, containerele nu au fost niciodată recuperate, dar anomalii asociate cu prezența gândacilor l-au determinat pe Sir Maurice Hankey, șeful efortului de război biologic al Marii Britanii, să scrie un memoriu lui Winston Churchill, exprimându-și îngrijorările. Aceasta nu este singura armă biologică presupusă cu insecte; pe măsură ce temerile de invazie britanică au crescut după evacuarea cu succes din Dunkirk, zvonurile s-au răspândit că germanii au creat o tulpină omnivoră de lăcustă, care avea să-i înfometeze pe britanici și să se predea. S-a dovedit că acesta era un mit.
Cu toate acestea, faptul că medicii nazisti au folosit subiecți umani pentru experimente cu boli transmise de insecte nu este un mit. Medicii SS din Natzweiler, Dauchau și Buchenwald au infestat intenționat cu păduchi infectați cu tifos deținuții. Mulți dintre acești medici și oameni de știință au fost condamnați la moarte de Tribunalul de la Nürnberg după război. Au fost, de asemenea, mai multe atacuri lansate împotriva Chinei de Japonia în perioada 1939-45; puricii infectați cu ciumă au fost pulverizați direct din aeronave sau prin intermediul unor bombe specializate care au desfășurat purici. În 1944, o echipă de asalt a fost adunată pentru a pulveriza purici infestați cu ciumă în jurul aerodromului Saipan, pe care americanii îl dețineau la acea vreme. Cu toate acestea, operațiunea a fost oprită după ce nava care transporta echipa de asalt a fost scufundată de un submarin american și experimentul nu a fost niciodată realizat. Dar pentru că atacul a eșuat nu înseamnă că alte atacuri nu au avut loc.
Nota editorului I.P.: Reportajele venind din partea presei jidănești cu privire la folosirea armelor biologice de către axă în al doilea război mondial trebuie privite cu scepticism. Hitler însuși a fost oripilat de folosirea armelor biologice în primul război mondial. De asemenea, “dovezile” și măturiile extrase prin tortură în farsa care a fost Tribunalul de la Nurnberg sunt lipsite de orice credibilitate.
Potențial unul dintre cele mai tulburătoare cazuri îl implică pe Dr. Shiro Ishii un microbiolog și un ofițer medical al armatei imperiale japoneze în timpul celui de-al doilea război sino-japonez și al doilea război mondial. Lui Ishii i-a fost pus în responsabilitate construirea și conducerea în unitatea 731, a unei instalații de cercetare și dezvoltare a armelor biologice de top-secret, conform „The Guardian” https://www.theguardian.com/world/2018/apr/17/japan-unit-731-imperial-army-second-world-war .
Unitatea 731 a fost înființată în nord-estul Chinei, într-un stat marionetă japonez, pe aproape 6 kilometri pătrați de pământ. Oficial, unitatea 731 a funcționat ca o instalație de purificare a apei și moară de cherestea, parte a Direcției de prevenire a epidemiei și purificare a apei din armata Kwantung. Ishii și alții care lucrau la unitatea 731 https://www.theguardian.com/world/2018/apr/17/japan-unit-731-imperial-army-second-world-war ar fi ucis în cele din urmă peste 10.000 de cetățeni chinezi și prizonieri de război (POWS).
Unitatea 731 a investigat https://dc.etsu.edu/cgi/viewcontent.cgi?article=2167&context=etd , printre multe lucruri deplorabile, cele mai bune combinații de boli și vectori pentru a ataca un inamic și cel mai bun mod de a introduce acel vector, prin alimentarea cu apă, aer și prin insecte, adică război entomologic.
Sovieticii au organizat și experimente cu purici în Mongolia înainte și în timpul războiului. Într-un experiment, prizonierii politici și prizonierii de război au fost înlănțuiți în țarcuri cu șobolani bolnavi, până când subiecții au fost mușcați de purici infectați. Se presupune că, în vara anului 1941, unul dintre prizonierii / subiecții experimentali a scăpat și a început o epidemie controlată doar pentru că sovieticii au bombardat întreaga comunitate mongolă.
În 1952, China a acuzat SUA că s-a angajat în război cu germeni împotriva oamenilor din Coreea de Nord. Chinezii au început să producă cantități mari de dovezi care sugerau că Statele Unite răspândeau insecte infestate de bacterii și alte obiecte în mediul rural coreean. De asemenea, diverse variante de ciumă au apărut brusc în zonele în care nu a existat o singură ciumă documentată timp de peste 500 de ani (în timpul războiului din Coreea). Entomologii chinezi au acuzat Statele Unite că au împrăștiat muște antomide și alte insect purtătoare de boli, cu avionul P-51. De asemenea, au fost nivelate acuzațiile care afirmă că America contamina zonele cu șobolani și purici infestați cu ciumă și muște și păianjeni infectate cu antrax. În total, S.U.A. au fost acuzate că arunca furnici, gândaci, greieri, purici, muște, lăcuste, păduchi, etc. Presupusele boli asociate includ antrax, holeră, dizenterie, septicemie de păsări, paratifoidă, ciuma, tifos scrub și tifoid, conform lui Peterson.
De asemenea, chinezii au înființat o comisie științifică internațională pentru investigarea faptelor despre războiul bacterian. Comisia, formată din oameni de știință din întreaga lume, a decis că Statele Unite s-au angajat probabil într-o război biologic limitat în Coreea.
În 1962, generalul Stubbs a trecut în palmares și a admis în Congres că se dezvoltă tulpini de insecte rezistente la insecticide. În sfârșit, în 1969, președintele Nixon s-a declarat pentru distrugerea unilaterală a armelor biologice. La doar trei ani mai târziu, SUA au semnat Convenția privind armele biologice, care a interzis dezvoltarea, producerea, stocarea, transferul și achiziționarea de arme biologice. În 1975, S.U.A. a semnat și Protocolul de la Geneva din 1925, care interzicea în continuare utilizarea acestor arme în război. Cu toate acestea, tratatele nu interzic națiunilor cercetarea, ceea ce, în cazul Statelor Unite, poate însemna că a continuat experimentele de război entomologic pe care l-a început pe purici, șobolani și alte creaturi care au fost folosite ca purtători de boli.
Timp de zeci de ani, armata americană a examinat dacă țânțarii infectați pot fi folosiți pentru a ucide dușmanii prin „războiul entomologic”. Unele dintre cele mai notabile experimente de război entomologic includ operațiunile Drop Kick, Big Buzz, May Day, Whitecoat, Big Itch și Bellweather. Și acestea sunt doar ceea ce există public și sunt declasificate. „În aceste extrase dintr-un raport al armatei din martie 1981, vă puteți mira cât de mult ar fi costat lansarea unui atac cu țânțari infectați cu febră galbenă într-un oraș (cu un grafic util„ Cost pe moarte ”inclus!).” relevă „Smoking Gun” https://archive.is/VeVbF .
Operațiunea Whitecoat: muște infectate testate pentru a mușca omul.
Operațiunea Big Itch : Au fost efectuate teste de teren pentru a determina modelele de acoperire și supraviețuirea șobolanilor infestați cu Cheopis Xenopsylla și purici tropicali pentru a fi utilizați ca vectori al bolii în războiul biologic.
Operațiunea Big Buzz: 1 milion A. Au fost produși țânțari Aedes Aeugupti, 1/3 au fost așezați în muniții și aruncați din aeronave sau dispersați pe sol. Țânțarii au supraviețuit atacului aerian și au căutat în mod activ sângele uman conform experimentului.
Operațiunea May Day: țânțarii Aedes Aegupti au fost dispersați în Georgia, SUA.
Operațiunea Bellweather : Comandamentul de Cercetare și Dezvoltare al Armatei SUA, Sucursala de Arme Biologice, a studiat activitatea de mușcătură a țânțarilor în aer liber, într-o serie de teste pe teren, la Dugway Proving Ground, Utah, în 1960. Femelele Aedes Aegypti, care au fost înfometate, au fost testate pe soldați în aer liber. Totuși, anumite părți din raportul armatei americane din 1981, cum ar fi „Producția în masă a lui Aedes Aegypti” nu au fost declasificate ca operațiunea Drop Drop Kick, care a fost redactată complet. Aceasta înseamnă că experimentele ar putea fi încă în desfășurare sub un nume diferit sau sub aceeași operațiune. Aedes Aegypti, cunoscut și sub numele de țânțarul febrei galbene, a fost utilizat pe scară largă în operațiunile militare ale Statelor Unite. Aceeași specie de țânțari se presupune că este cauza dengue, chikungunya și chiar virusul Zika.
Țânțarul febrei galbene (Aedes Aegypti).
Dacă actuala revizuire a Congresului SUA stabilește că Pentagonul a creat insecte ca arme biologice, Casa Albă solicită inspectorului general să prezinte Congresului informații, inclusiv „dacă căpușele sau insectele utilizate în astfel de experimente au fost eliberate în afara laboratorului accidental sau proiectarea experimentului.” Este un adevăr neobservant că guvernul ar putea fi responsabil pentru faptul că a dezlănțuit un agent patogen personalizat ca parte a unui experiment biologic uman. Chiar dacă din greșeală (ceea ce este mai puțin probabil dat fiind eliberarea deliberată insectelor înarmate de mai sus), nici nu este atât de bizar.
În 2009, agenția germană de știri „Spiegel” https://www.spiegel.de/international/zeitgeist/virus-alarm-in-switzerland-swine-flu-container-explodes-on-train-a-621598.html a raportat că un container de gripă porcină a explodat într-un tren din Elveția. Este posibil să fi fost cauza din spatele focarului de gripă porcină din același an, în ciuda negării din articol.
,,În mijlocul temerilor globale de pandemie de gripă porcină, un container cu gripă porcină a explodathttps://www.spiegel.de/international/world/fears-of-swine-flu-pandemic-eu-advises-travellers-to-avoid-mexico-and-us-a-621494.html într-un tren care transporta peste 60 de persoane”. „Din fericire, cu toate acestea, virusul gripei porcine nu a fost cel care a ucis aproximativ 150 de persoane în Mexic. Poliția a liniștit rapid publicul că nu există niciun pericol de infecție.”
De asemenea, China a avut, un incident de focar, care a condus la cinci oficiali de top ai Centrului Chinez pentru Controlul și Prevenirea Bolilor (CDC) de a fi pedepsiți pentru focarul de SARS. Ancheta a descoperit că eliberarea virusului s-a datorat neglijenței a doi angajați ai CDC care au fost infectați și care nu au fost decontaminați, a informat „China Daily” http://www.chinadaily.com.cn/english/doc/2004-07/02/content_344755.htm .
În 2014, un om de știință – Yoshihiro Kawaoka, de la Universitatea din Wisconsin-Madison – a manipulat genetic tulpina virusului gripal pandemic H1N1 din 2009, gripa porcină, pentru a „scăpa” de controlul anticorpilor neutralizatori ai sistemului imunitar, făcând eficient populația umană fără apărare împotriva reemergenței sale, a relatat Independent https://www.independent.co.uk/news/science/exclusive-controversial-us-scientist-creates-deadly-new-flu-strain-for-pandemic-research-9577088.html în Marea Britanie.
În același an, oamenii de știință de la aceeași Universitate din Wisconsin-Madison, în frunte cu Kawaoka, au creat un virus care pune în pericol viața, ce seamănă îndeaproape cu tulpina de gripă spaniolă din 1918 care a ucis aproximativ 50 de milioane de oameni, acesta fiind condamnathttps://www.theguardian.com/science/2014/jun/11/crazy-dangerous-creation-deadly-airborne-flu-virus de colegii lui ca fiind „nebun”.
Anul trecut, un raport http://www8.nationalacademies.org/onpinews/newsitem.aspx?RecordID=24890&_ga=2.46750624.683097205.1529461315-249381298.1529461315 major al Academiilor Naționale de Științe, Inginerie și Medicină se adresa guvernului American și avertiza că progresele în biologia sintetică permit acum oamenilor de știință capacitatea de a recrea viruși periculoși de la zero, fac bacteriile dăunătoare să fie mortale și modifică microbii obișnuiți, astfel încât să elimine toxinele letale odată ce au intrat în organism. Raportul nu menționa armele de război entomologice.
Conform „The Guardian” https://www.theguardian.com/science/2018/jun/19/urgent-need-to-prepare-for-manmade-virus-attacks-says-us-government-report : „În raport, oamenii de știință descriu cum biologia sintetică, care oferă cercetătorilor instrumente de precizie pentru a manipula organismele vii, «îmbunătățește și extinde» oportunitățile de a crea bioarme. «Pe măsură ce puterea tehnologiei crește, aceasta aduce o nevoie generală de a examina de unde ar putea provoca daunele.», a spus Peter Carr, un om de știință principal al Centrului de Biologie Sintetică MIT din Cambridge, Massachusetts.”
„Raportul solicită guvernului american să regândească modul în care conduce supravegherea bolii, astfel încât să poată detecta mai bine bioarmele și să analizeze modalitățile de a consolida apărările, de exemplu, găsind modalități de a face și de a desfășura vaccinuri mult mai rapid. Pentru fiecare bioarmă oamenii de știință consideră, obstacole cheie care, odată șterse, vor face armele mai fezabile.”
Dacă SUA au folosit boli purtate de vectori, precum ciuma (purtată de purici), febra galbenă și malaria (țânțarii), tifos (păduchi), febra Q (căpușe) și dizenterie (muște) în conflicte din campaniile napoleoniene până în Primul Război Mondial, ce a oprit continuarea acelor experimente de război entomologic până în epoca modernă pe căpușe cu boala Lyme? Răspunsul este: absolut nimic. Este clar că există o umbrelă a Pentagonului cu experimentele din armată a războiului entomologic, iar acum guvernul ar trebui să compenseze milioane de americani care ar fi putut fi infectați de la eliberarea ascunsă de agenți patogeni după ce au fost supuși insectelor și animalelor deopotrivă.
Aaron KESSEL
Sursa: http://humansarefree.com via https://burebista2012.blogspot.com/
Lectură suplimentară: http://humansarefree.com/2018/10/darpa-plans-to-spread-viruses-using.html
Incorect Politic O Publicație Dizidentă